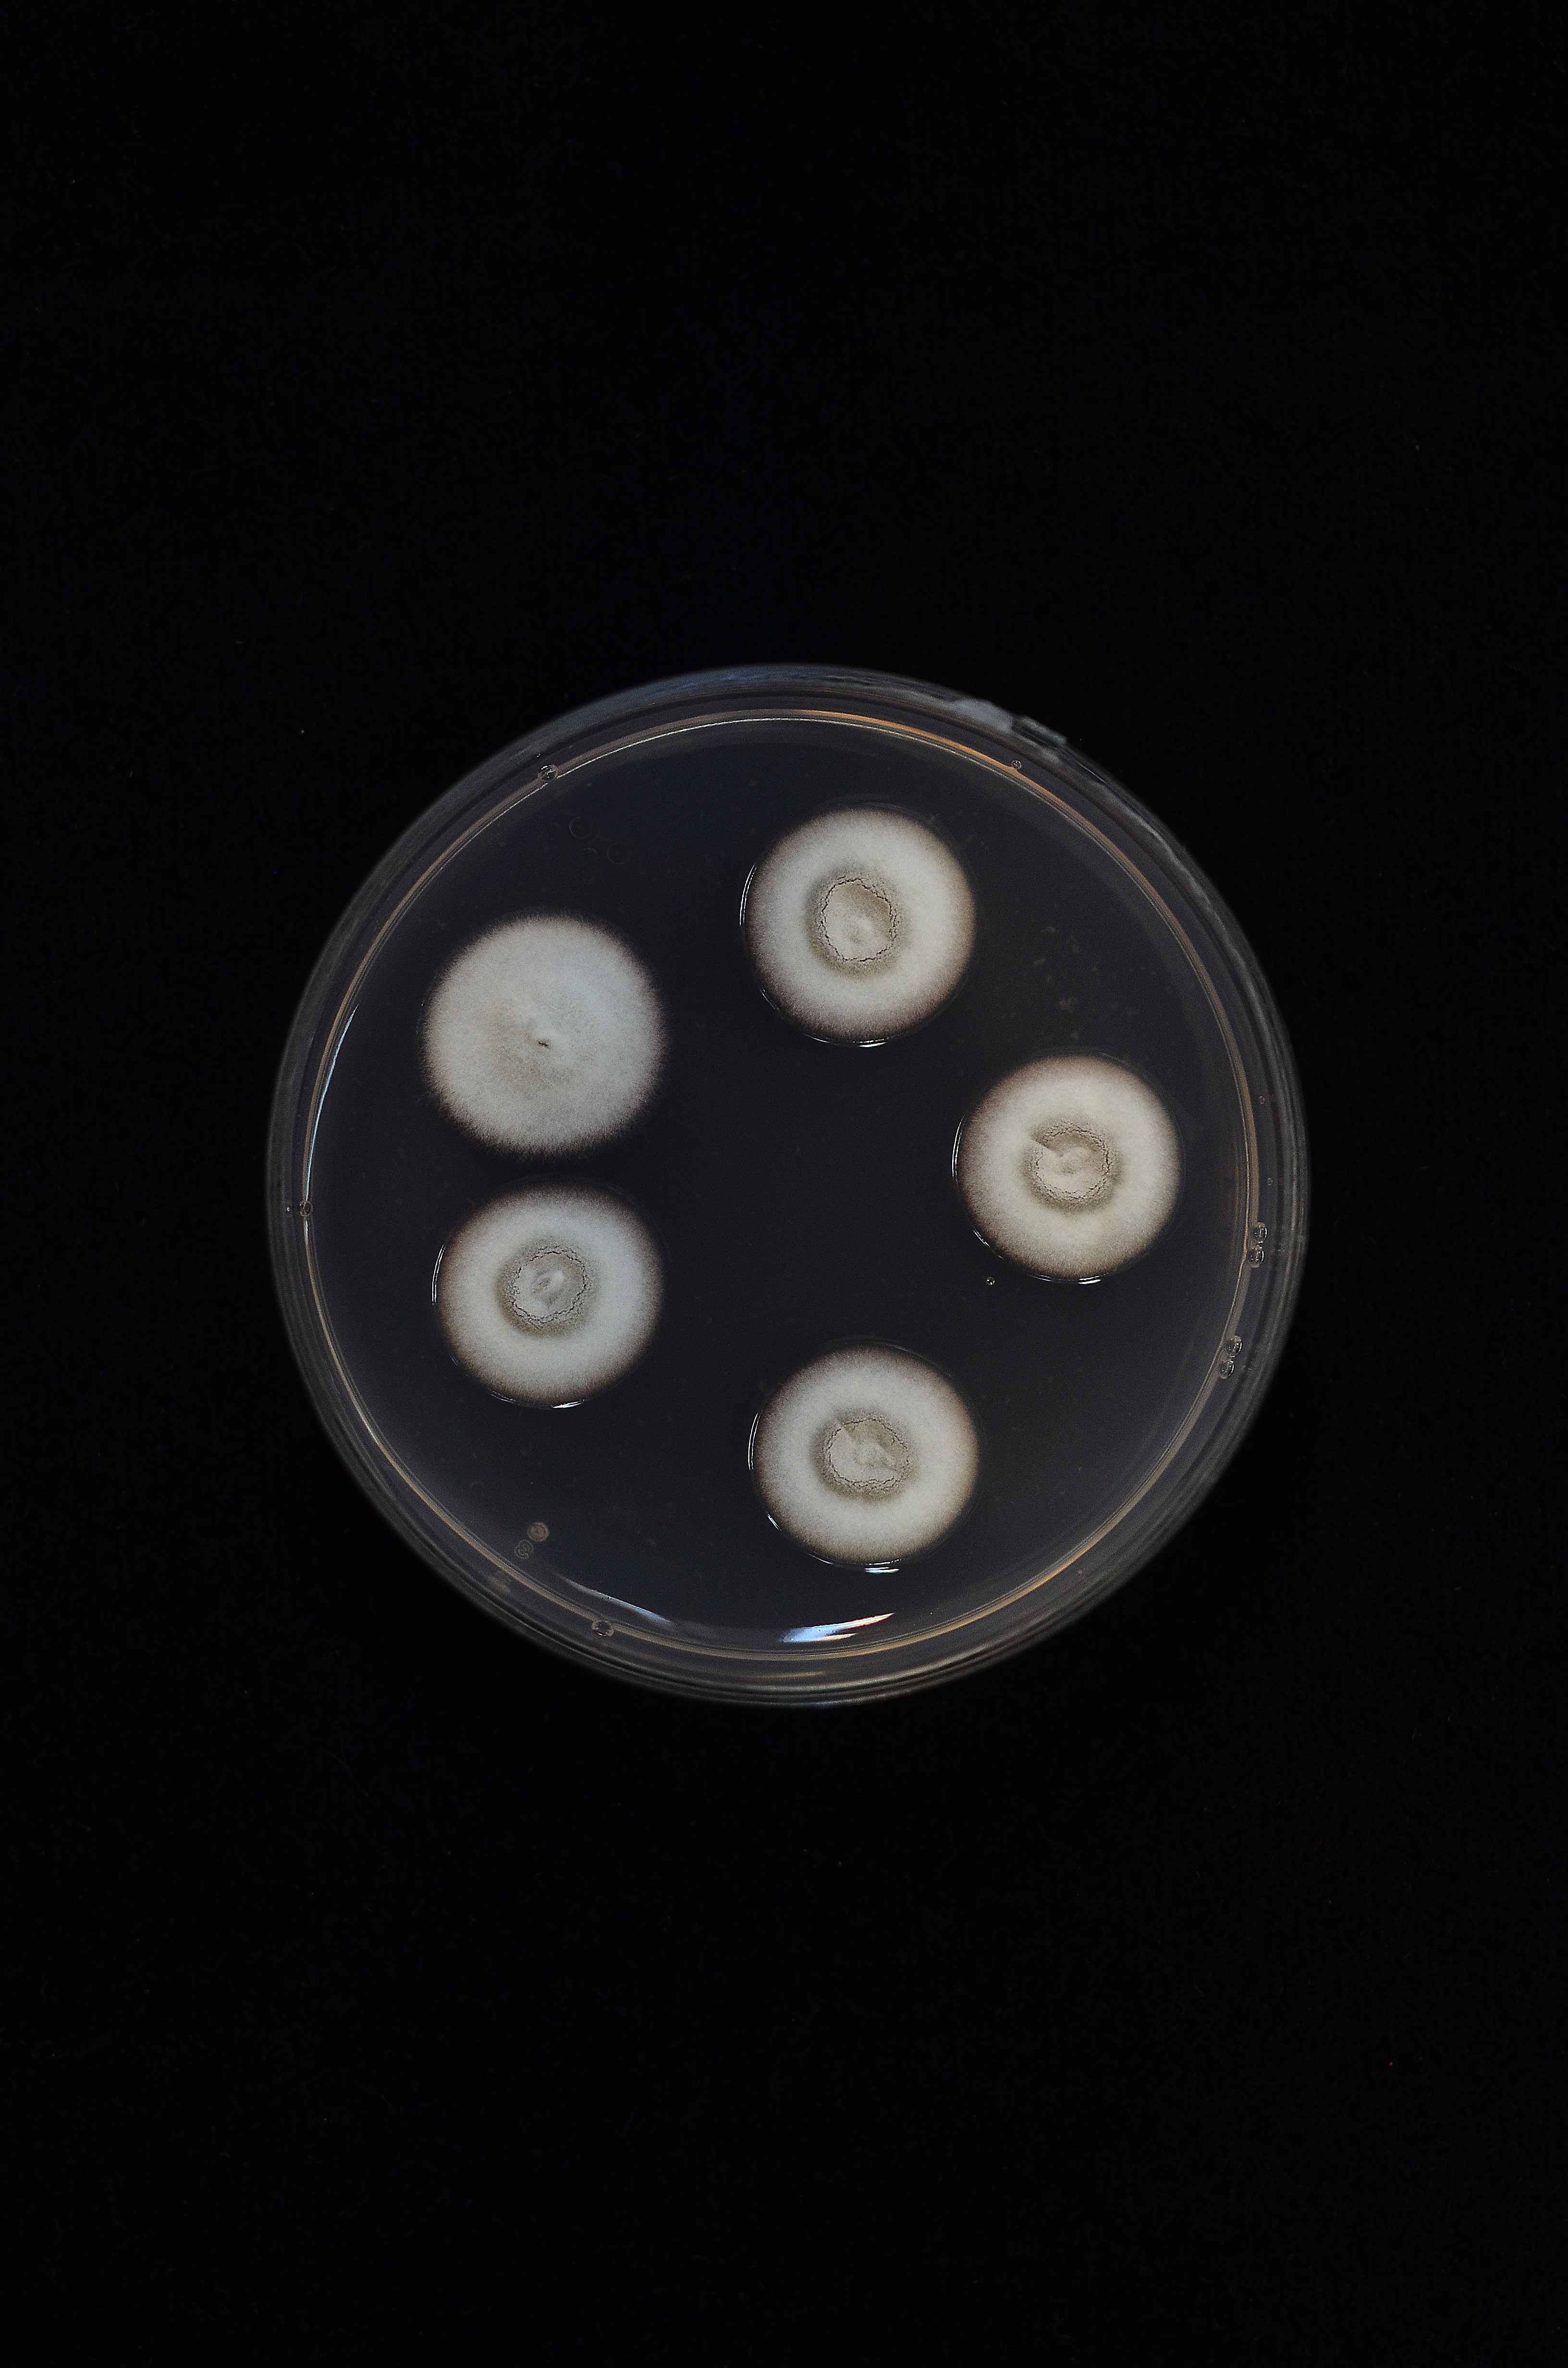

Holotype:
THAILAND, Nakom Nayok Province, Khao Yai National Park, 16 Jul. 1991, Hywel-Jones NL, holotype NHJ539.02.
Habitat:
Buried in soil.
Host:
On Elaterid beetle larvae.
Description:

Stroma usually solitary, rarely up to 3, simple, 25–90 mm long. Stipe simple, cylindrical, base reddish-brown, head distinct, subterminal, cinnamon with brown dots. The fertile head was distinctly sub-terminal with anamorph state at apex. 
Perithecia immersed, brown, ovate to pyriform, 270–335 × 110–160 μm. 
Asci hyaline, cylindrical, capitate, 8-spored, 280–295 × 6–7 μm. 
Ascospores hyaline, filiform, multi-septate breaking into 64 parts-pores, cylindrical and truncated at the ends, 4–6 × 1–1.5 μm. Asexual morph: synnematous, terminal, pale grey-brown to white, 8–12 mm long. 
Conidiogenous cells monophialidic, rarely polyphialidic, hyaline, smooth, 5–8 × 2.5–3 μm. 
Conidia hyaline, smooth, spherical, 1.5–2.5 μm diam, enveloped by a mucous sheath.
Culture characteristics:
Colonies on PDA attaining a diam of 10–12 mm in 14 d. Colonies at first white changing to cinnamon brown with age. 
Conidiogenous cells monophialidic, up to 25 μm long, 1–3 μm wide. 
Conidia, hyaline, smooth, 2–5 × 2–5 μm.
Reference:
Hywel-Jones NL (1995). Cordyceps brunneapunctata sp. nov. infecting beetle larvae in Thailand. Mycological Research 99: 1195–1198.
DOI: https://doi.org/10.1016/S0953-7562(09)80277-3Species |
Strain |
Compound |
Pubchem CID |
Biological activity |
Reference |
|---|
|
Strain |
- |
|---|---|
| BCC 2218 | - |
| BCC 43276 | - |
| BCC 48060 | - |
| BCC 48686 | - |